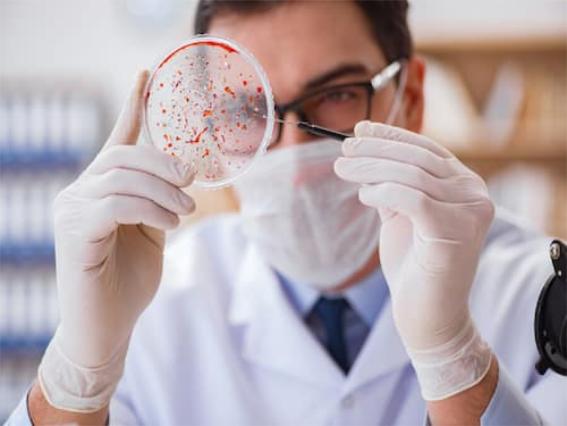

WHO cảnh báo vi khuẩn gây nhiễm trùng máu có thể kháng thuốc kháng sinh cuối cùng
Khoảng 8% các ca nhiễm trùng máu đe dọa đến tính mạng do vi khuẩn K.pneumoniae gây ra có khả năng kháng thuốc kháng sinh cuối cùng, như carbapenem.
Trong một báo cáo mới, WHO đã tiết lộ mức độ kháng kháng sinh cao (trên 50%) đối với các vi khuẩn như Klebsiella pneumoniae (K. pneumoniae) và Acinetobacter spp.
Những bệnh nhiễm trùng đe dọa tính mạng này cần được điều trị bằng kháng sinh cuối cùng, chẳng hạn như carbapenem. Tuy nhiên, 8% các ca nhiễm trùng máu do K.pneumoniae gây ra đã được báo cáo là kháng carbapenem, làm tăng nguy cơ tử vong do nhiễm trùng khó kiểm soát.
Vi khuẩn gây nhiễm trùng máu có thể kháng đến kháng sinh cuối cùng…
Vi khuẩn gây nhiễm trùng máu có thể kháng đến kháng sinh cuối cùng…
Nhiều bệnh nhiễm trùng do vi khuẩn trở nên đề kháng với các phương pháp điều trị
Ngoài K.pneumoniae, nhiều bệnh nhiễm trùng do vi khuẩn phổ biến khác cũng đang ngày càng kháng lại các phương pháp điều trị.
Vi dụ: Vi khuẩn Neisseria gonorrhoea gây bệnh lậu, một bệnh lây truyền qua đường tình dục phổ biến. Hơn 60% các chủng Neisseria lậu cầu đã trở nên kháng ciprofloxacin, một trong những loại thuốc kháng sinh đường uống được sử dụng nhiều nhất.
E.coli, nguyên nhân phổ biến nhất gây nhiễm trùng đường tiết niệu. Hơn 20% các chủng E.coli được báo cáo là kháng cả thuốc điều trị đầu tay (ampicillin và co-trimoxazole) và phương pháp điều trị thứ hai (fluoroquinolones).
Hơn một triệu người chết mỗi năm do vi khuẩn kháng kháng sinh
 Vi khuẩn kháng thuốc khiến cho các bệnh nhiễm trùng thông thường do vi khuẩn trở nên khó điều trị.
Vi khuẩn kháng thuốc khiến cho các bệnh nhiễm trùng thông thường do vi khuẩn trở nên khó điều trị.
Tình trạng kháng kháng sinh ngày càng tăng, do sử dụng quá mức và lạm dụng kháng sinh và các thuốc chống vi trùng khác, đang đặt ra mối đe dọa nghiêm trọng đối với con người, động vật, thực vật, hệ sinh thái và sinh kế.
Theo WHO, tình trạng kháng kháng sinh của vi khuẩn (AMR) gây ra ước tính 1,3 triệu ca tử vong trên toàn thế giới mỗi năm. Con số này có thể tăng lên đáng kể, nếu không có hành động nào được thực hiện để chống lại mối đe dọa ngày càng tăng, đặc biệt là ở các nước có thu nhập thấp.
Kháng kháng sinh xảy ra khi các tác nhân gây bệnh như vi khuẩn, virus, nấm và ký sinh trùng phát triển khả năng sống sót trước các tác nhân kháng vi sinh vật được thiết kế để loại bỏ chúng.
Khi các loại thuốc này mất tác dụng, việc điều trị nhiễm trùng trở nên khó khăn hoặc không thể, dẫn đến tăng nguy cơ lây lan bệnh, bệnh nặng và tử vong./.
Bích Ngọc (Sức khỏe và Đời sống)






